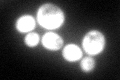
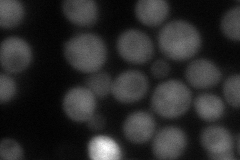
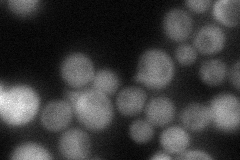
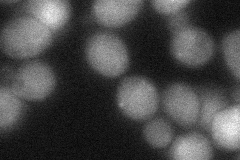

View description
Putative protein of unknown function; green fluorescent protein (GFP)-fusion protein localizes to the cytoplasm and nucleus; YER067W is not an essential gene; protein abundance is increased upon intracellular iron depletion
Localization:
Intensity:
Fold change:
Significance:
-
C’ GFP library in SD
cytosol168.42 -
N' NOP1pr-GFP in SD

cytosol56.61 -
N' TEF2pr-mCherry in SD
cytosol75.7015 -
N' NATIVEpr-GFP in SD
cytosol50.5881 -
N' TEF2pr-VC and Cyto-VN in SD
cytosol52.5429 -
C’ GFP library in SD+DTT

cytosol186.81.1No -
C’ GFP library in SD+H2O2

cytosol167.860.99No -
C’ GFP library in Starvation Media

cytosol74.310.44Yes -
C’ GFP library on the background of Pup2-DaMP

cytosol -
C’ GFP library on the background of CCT mutant

cytosol148.4550.881408No
